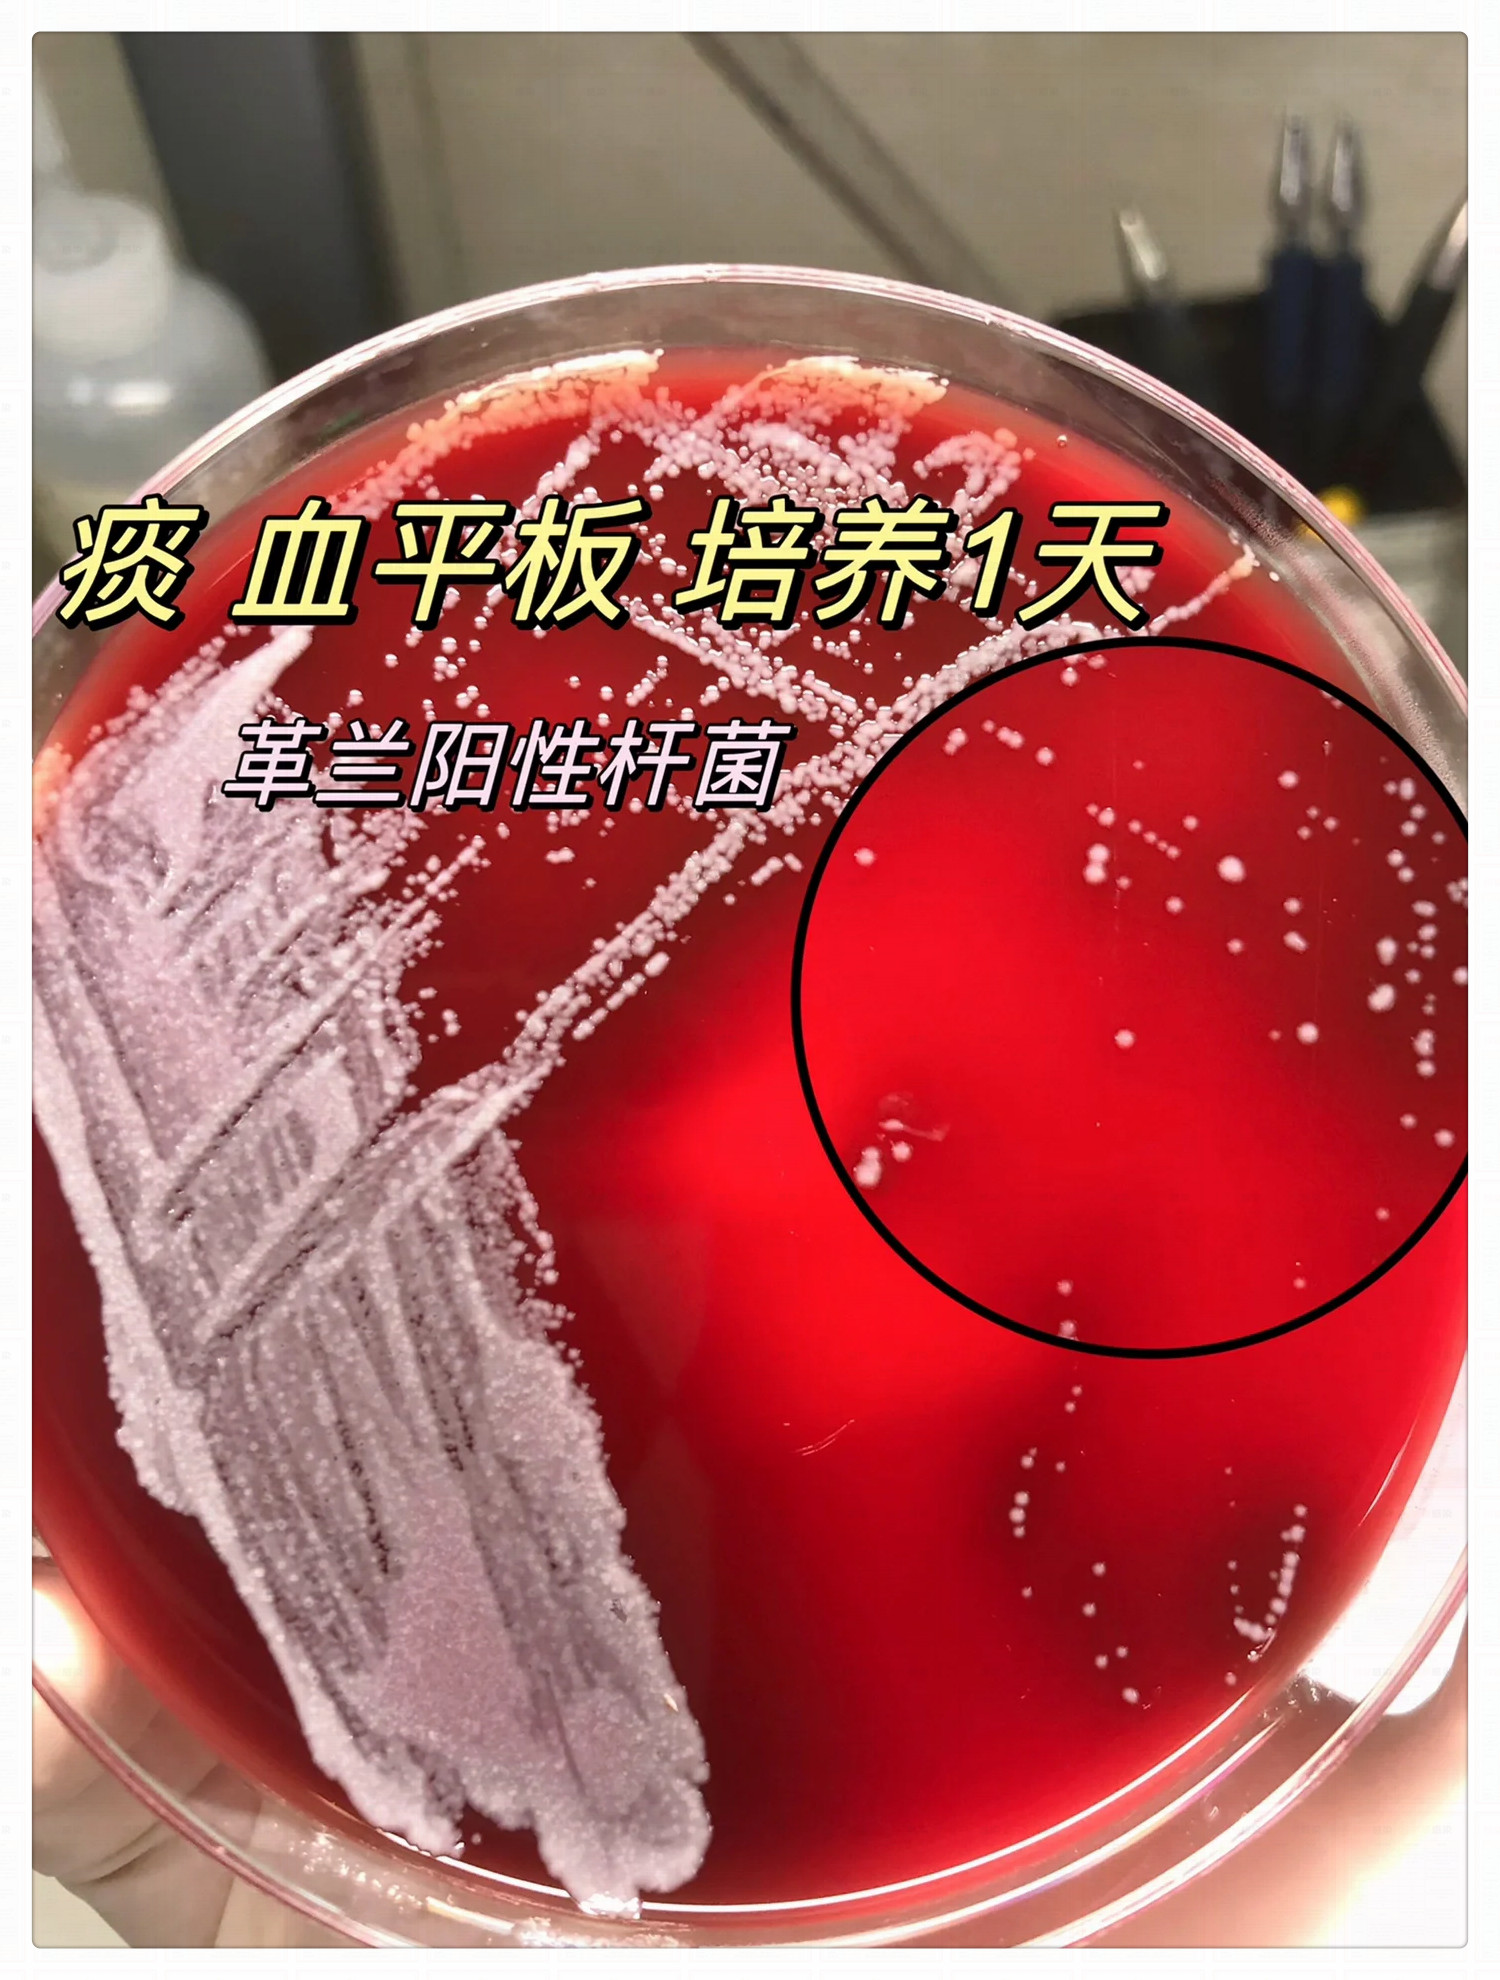
什么是革兰氏阳性菌

儿童血液病早期症状特点
1、1 发热发热是儿童白血病最常见的症状之一,可能表现为低热或高热,且持续时间较长与普通感染不同,此类发热使用抗生素治疗通常无效,需警惕血液系统疾病的可能2 贫血白血病患儿常因骨髓造血功能受抑制而出现贫血,表现为面色...
慢性支气管炎要如何调理
一中医调理辨证施治,改善体质中医认为慢性支气管炎与肺热肺寒或肺气虚相关,需通过“望闻问切”诊断患者体质后开方例如,肺热者可能用清热化痰方剂,肺气虚者则需补益肺气长期调理可增强肺功能,减少痰液生成,但需坚持用药并定期复...
肩周炎自我疗法有哪些(肩周炎肩痛的自我运动康复疗法之肩关节拉伸)
上一期为大家介绍了肩膀疼痛的相关内容,有些已经患有肩周炎的朋友向我建议,希望我写一写有关肩关节功能锻炼的文章。今天,我就跟大家介绍一下肩周炎的自我运动疗法。实际上,对写肩痛的自我康复,我一直心存顾虑。原因就是怕对大家...
樱桃吃多了会上火吗(夏天吃樱桃会中毒一次吃很多才会中毒)
进入夏天,食用水果,无疑是很多人比较喜欢做的事情,多种水果上市,让人很好地满足味蕾的享受,其中,以樱桃来说,是不可少的常见水果,吃樱桃对身体是极好的,能够很好地滋补身体、美容养颜、补血等。但是,在网络上也不乏看到这样...
膝盖弯曲伸直有响声但是不疼,该怎么办(一弯膝盖)
来跟我做一个动作,把你的手按在你的膝盖前方,然后去弯曲和伸直膝关节,有多少人能感觉到里面有明显的沙沙的摩擦感,甚至说咔咔响,有的人还伴有疼痛,为什么会有这样的情况呢?...

京公网安备11000000000001号
京ICP备11000001号